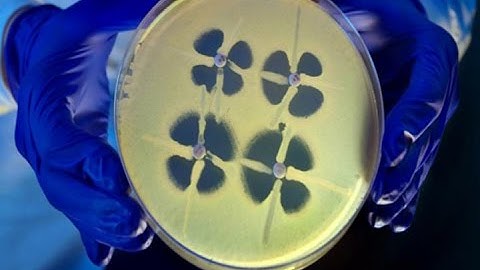
Superbug Scare, 2 Dead 179 Exposed at UCLA Medical Center

⬇ DOWNLOAD NOW
Kalau muncul iklan pop-up, tutup lalu klik tombol kembali
Download lagu Deadly superbug scare: FDA warns doctors to properly sterilize devices secara gratis hanya untuk keperluan promosi. Dukung artis favorit kamu dengan membeli musik original di iTunes atau platform resmi lainnya.
 Watch Out for Endoscopes Linked to Superbug Outbreak, FDA Says
Watch Out for Endoscopes Linked to Superbug Outbreak, FDA Says
Superbug Scare, 2 Dead 179 Exposed at UCLA Medical Center
Superbug Scare, 2 Dead 179 Exposed at UCLA Medical Center
 Video: Bacteria robot to sterilize against superbug
Video: Bacteria robot to sterilize against superbug
 Officials investigate "superbug" outbreak at UCLA medical center
Officials investigate "superbug" outbreak at UCLA medical center
 Reusable Medical Device May Be Spreading ‘Superbug’
Reusable Medical Device May Be Spreading ‘Superbug’
 Deadly 'Superbugs' Plaguing Hospitals
Deadly 'Superbugs' Plaguing Hospitals
 Superbug scare: What is it?
Superbug scare: What is it?
 Warning over superbug threat
Warning over superbug threat